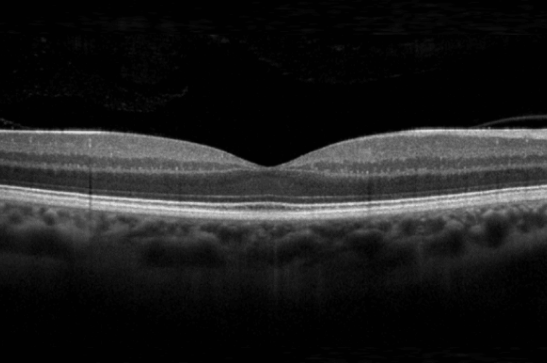

Membro da Sociedade Brasileira de Glaucoma

● Graduação em Medicina pela Universidade Federal de Pelotas (2017).
● Residência Médica em Oftalmologia no Hospital Santa Casa, pela Universidade Federal de Ciências da Saúde de Porto Alegre.
● Fellowship em Glaucoma no Hospital Banco de Olhos de Porto Alegre.
● Aperfeiçoamento Internacional em Glaucoma pela Washington University in St. Louis, Missouri, USA.
Cirurgia de Facoemulsificação: Procedimento minimamente invasivo que utiliza tecnologia ultrassônica para remover o cristalino opaco (catarata) e implantar uma lente intraocular. É a técnica padrão de excelência.

Avalia o campo visual do paciente, identificando áreas de visão perdida ou reduzida, essencial no diagnóstico e controle do glaucoma e distúrbios neurológicos.










O Hospital de Olhos de Pelotas é uma referência na região, oferecendo equipamentos de última geração, uma equipe altamente qualificada e uma estrutura acolhedora para garantir o melhor atendimento aos pacientes.







contato@drwilliamzibetti.com.br
Hospital de Olhos Pelotas
R. Santos Dumont, 200 – Centro – Pelotas/RS